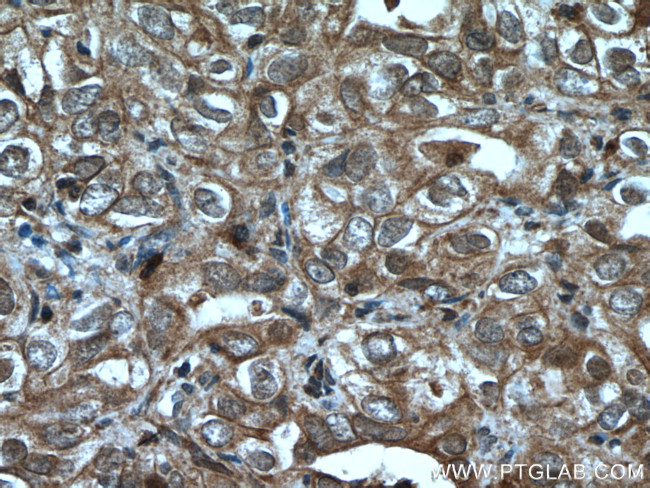
UBE2B Antibody in Immunohistochemistry (Paraffin) (IHC (P))

Search
Proteintech
UBE2B Polyclonal Antibody
{{$productOrderCtrl.translations['antibody.pdp.commerceCard.promotion.promotions']}}
{{$productOrderCtrl.translations['antibody.pdp.commerceCard.promotion.viewpromo']}}
{{$productOrderCtrl.translations['antibody.pdp.commerceCard.promotion.promocode']}}: {{promo.promoCode}} {{promo.promoTitle}} {{promo.promoDescription}}. {{$productOrderCtrl.translations['antibody.pdp.commerceCard.promotion.learnmore']}}
产品信息
10733-1-AP
种属反应
已发表种属
宿主/亚型
分类
类型
抗原
偶联物
形式
浓度
规格
纯化类型
保存液
内含物
保存条件
运输条件
产品详细信息
Immunogen sequence: MSTPARRRL MRDFKRLQED PPVGVSGAPS ENNIMQWNAV IFGPEGTPFE DGTFKLVIEF SEEYPNKPPT VRFLSKMFHP NVYADGSICL DILQNRWSPT YDVSSILTSI QSLLDEPNPN SPANSQAAQL YQENKREYEK RVSAIVEQSW NDS (1-152 aa encoded by BC005979)
靶标信息
The modification of proteins with ubiquitin is an important cellular mechanism for targeting abnormal or short-lived proteins for degradation. Ubiquitination involves at least three classes of enzymes: ubiquitin-activating enzymes, or E1s, ubiquitin-conjugating enzymes, or E2s, and ubiquitin-protein ligases, or E3s. UBE2B is a member of the E2 ubiquitin-conjugating enzyme family. This enzyme is required for post-replicative DNA damage repair. Its protein sequence is 100% identical to the mouse, rat, and rabbit homologs, which indicates that this enzyme is highly conserved in eukaryotic evolution.
仅用于科研。不用于诊断过程。未经明确授权不得转售。
生物信息学
蛋白别名: E2 protein; E2 ubiquitin-conjugating enzyme B; E2(14k); E214K; HHR6B (Human homologue of yeast RAD 6); putative; HR6B; RAD6 homolog B; UBE2B; Ubiquitin carrier protein B; ubiquitin conjugating enzyme; ubiquitin conjugating enzyme E2B; Ubiquitin-conjugating enzyme E2 B; Ubiquitin-conjugating enzyme E2(14k); Ubiquitin-conjugating enzyme E2-17 kDa; ubiquitin-conjugating enzyme E2B (RAD6 homolog); ubiquitin-conjugating enzyme E2B (RAD6 homolog, S. cerevisiae); ubiquitin-conjugating enzyme E2B, RAD6 homolog; ubiquitin-conjugating enzyme E2B, RAD6 homology; Ubiquitin-protein ligase B; unnamed protein product
基因别名: 2610301N02Rik; E2-14k; E2-17kDa; HHR6B; HR6B; mHR6B; RAD6B; UBC2; UBCH1; UBE2B
UniProt ID: (Human) P63146, (Rat) P63149, (Mouse) P63147
Entrez Gene ID: (Human) 7320, (Rat) 81816, (Mouse) 22210